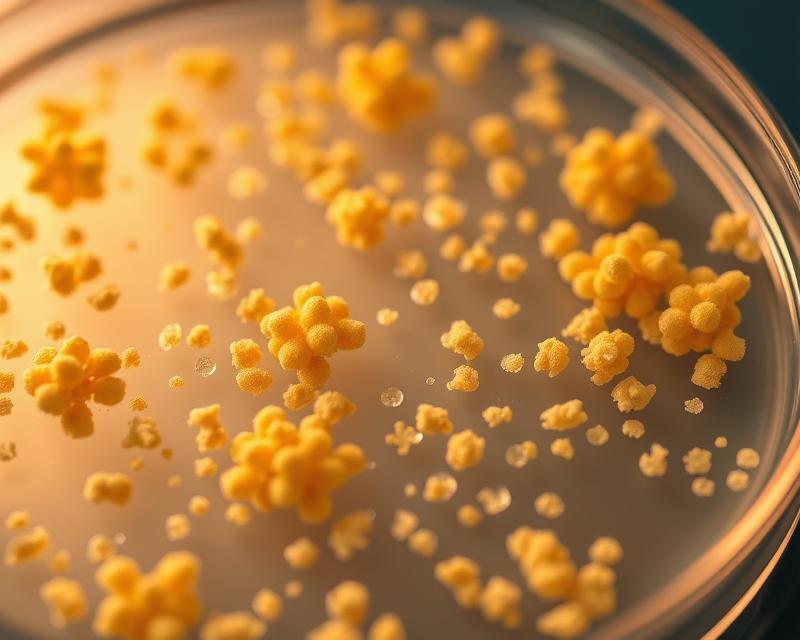

Gronkowiec: co to jest i jak zapobiegać zakażeniom?
Gronkowiec, niewidoczny dla oka, ale obecny w naszym otoczeniu, to rodzaj bakterii, który może być zarówno częścią naturalnej flory bakteryjnej, jak i groźnym patogenem. Oto bakterie Gram-dodatnie, które mogą zaskoczyć nas swoją wszechobecnością oraz zdolnością do wywoływania poważnych infekcji. Szczególnie niebezpieczny jest gronkowiec złocisty, który potrafi żyć w naszym organizmie przez lata, nie dając żadnych objawów, by w odpowiednich warunkach zaatakować z pełną siłą. Zrozumienie tej bakterii, jej rodzajów oraz potencjalnych zagrożeń, które niesie ze sobą, staje się kluczowe dla zdrowia publicznego. W miarę jak rośnie liczba zakażeń, które mogą prowadzić do groźnych powikłań, pytania dotyczące gronkowców stają się coraz bardziej aktualne.
Co to jest gronkowiec i jakie ma cechy?
Gronkowce to rodzaj bakterii, które naturalnie bytują w ludzkich organizmach. Należą do grupy Gram-dodatnich i obejmują wiele różnych gatunków. W kontekście zdrowia człowieka najbardziej istotne są:
- gronkowiec złocisty (Staphylococcus aureus),
- gronkowiec epidermidis,
- gronkowiec haemolyticus.
Te mikroorganizmy wykazują niesamowitą zdolność adaptacji, co pozwala im funkcjonować w obecności lub braku tlenu. Co więcej, nie tworzą przetrwalników, co może wpływać na ich przetrwanie w zróżnicowanych środowiskach.
Gronkowce charakteryzują się również zdolnością do tworzenia charakterystycznych kolonii przypominających kiście winogron, co łatwo dostrzega się pod mikroskopem. Gronkowiec złocisty, będący najgroźniejszym z tej grupy, może wywoływać poważne infekcje – od prozaicznych problemów skórnych po zagrażające życiu zakażenia ogólnoustrojowe. Warto zauważyć, że wiele osób nosi te bakterie, nie mając żadnych objawów. Ta bezobjawowość stanowi istotne wyzwanie w diagnostyce i leczeniu zakażeń. Z moich doświadczeń wynika, że często gronkowiec złocisty nie daje symptomów, co prowadzi do nieświadomego rozprzestrzeniania się tych bakterii.
Bakterie te można klasyfikować w zależności od obecności enzymu koagulazy, dzieląc je na:
- koagulazododatnie,
- koagulazoujemne.
Gronkowiec złocisty znajduje się w pierwszej grupie. Ich rola w medycynie jest nie do przecenienia, zwłaszcza w kontekście zakażeń szpitalnych, gdzie wykazują znaczną odporność na wiele antybiotyków. Ta oporność różni się w zależności od regionu oraz specyficznego szczepu i może wpłynąć na stosowane strategie leczenia.
Jakie są rodzaje gronkowców i ich znaczenie?
Gronkowce to bakterie z rodzaju Staphylococcus, dzielące się na dwa główne typy: koagulazododatnie i koagulazoujemne. Najbardziej rozpoznawalnym gatunkiem jest gronkowiec złocisty (Staphylococcus aureus), który stanowi istotny rezerwuar gronkowców w organizmach ludzkich. Często dochodzi do zakażeń, takich jak:
- zapalenie płuc,
- zapalenie skóry,
- infekcje ran.
Gronkowce koagulazoujemne, chociaż uznawane za mniej niebezpieczne, stanowią istotny problem w kontekście zakażeń szpitalnych. Odpowiadają za infekcje u osób z osłabionym układem immunologicznym, w tym pacjentów po operacjach oraz tych z przewlekłymi schorzeniami. Zakażenia związane z tymi bakteriami mogą prowadzić do poważnych powikłań, jak sepsa.
Zrozumienie różnych rodzajów gronkowców oraz ich wpływu na rozwój infekcji jest kluczowe dla skuteczniejszego diagnozowania i leczenia tych dolegliwości. W moim doświadczeniu istotne jest, by wiedzieć, które bakterie odpowiadają za konkretne zakażenia. Ta wiedza jest niezbędna do poprawy zdrowia pacjentów.
Kto jest najbardziej narażony na zakażenia gronkowcem?
Największe ryzyko zakażeń gronkowcem dotyczy osób z osłabionym układem immunologicznym. W grupie podwyższonego ryzyka znajdują się zwłaszcza:
- pacjenci hospitalizowani,
- dzieci poniżej piątego roku życia,
- osoby starsze.
- ci, którzy przyjmują leki tłumiące odporność,
- osoby posiadające ciała obce, takie jak protezy czy wkłucia centralne.
Zakażenia gronkowcem mogą zdarzać się nawet u osób zdrowych, jednak najczęściej występują u tych borykających się z chorobami, takimi jak:
- nowotwory,
- HIV,
- przewlekłe schorzenia.
Również osoby prowadzące intensywny tryb życia, narażone na stres i zmęczenie, a także te, które nie dbają o właściwą dietę, stają się łatwiejszym celem dla infekcji.
Na szczęście, zdrowy styl życia i odpowiednia profilaktyka mogą znacząco obniżyć ryzyko zachorowań. Z mojego doświadczenia wynika, że te działania naprawdę przynoszą wymierne korzyści.
Jak dochodzi do zakażenia gronkowcem?
Zakażenie gronkowcem najczęściej przenosi się przez bezpośredni kontakt z osobą, która jest zakażona. Bakterie mają tendencję do łatwego rozprzestrzeniania się w różnych środowiskach. Można się nimi zarazić poprzez:
- dotykanie osób z infekcjami skórnymi,
- kontakt z przedmiotami, na których znajdują się patogeny,
- zanieczyszczone ręce,
- kontakt z krwią lub płynami ustrojowymi w warunkach klinicznych.
W miejscach publicznych, takich jak baseny, siłownie czy przychodnie, ryzyko zakażenia znacząco rośnie. Bakterie te stanowią poważne zagrożenie w placówkach medycznych, ponieważ osłabieni pacjenci są bardziej narażeni na infekcje. Dlatego tak istotne jest przestrzeganie zasad higieny rąk.
Regularne mycie rąk, zwłaszcza po kontakcie z potencjalnie zainfekowanymi powierzchniami, może skutecznie obniżyć ryzyko zakażeń, zarówno w szpitalach, jak i w codziennym życiu.
Jakie są objawy zakażenia gronkowcem?
Objawy zakażenia gronkowcem mogą się różnić w zależności od miejsca infekcji oraz konkretnego szczepu bakterii, z gronkowcem złocistym na czoło. Zakażenia skórne często manifestują się:
- bolesnymi czyrakami,
- ropniami,
- liszajcem,
- stanami zapalnymi.
Ważne jest, aby pamiętać, że takie dolegliwości mogą prowadzić do poważniejszych komplikacji, takich jak zapalenie powięzi.
Kiedy mówimy o infekcjach ogólnoustrojowych, objawy są nieco inne i mogą obejmować:
- wysoką gorączkę,
- ogólne złe samopoczucie.
Uważność na te symptomy jest niezwykle istotna, ponieważ mogą one wskazywać na rozwijającą się sepsę, co stanowi poważne zagrożenie dla zdrowia.
Nie można też pomijać innych klinicznych oznak. Warto zwrócić uwagę na:
- czerwone zabarwienie skóry,
- ropny wysięk,
- ból w miejscu infekcji.
W przypadku podejrzenia zakażenia gronkowcem niezbędne są badania bakteriologiczne, które pomogą w postawieniu prawidłowej diagnozy oraz wdrożeniu odpowiednich działań terapeutycznych.
Jakie są typowe infekcje wywoływane przez gronkowca?
Gronkowiec, zwłaszcza gronkowiec złocisty, może powodować różnorodne infekcje w różnych częściach ciała. Do najczęstszych należą:
- zapalenia płuc,
- zapalenia opon mózgowo-rdzeniowych,
- zakażenia dróg moczowych,
- bakteriemia,
- ropnie okołomigdałkowe.
Zapalenia płuc często mają ciężki przebieg i mogą wymagać hospitalizacji, szczególnie u osób z osłabionym układem odpornościowym. Zapalenia opon mózgowo-rdzeniowych mogą prowadzić do poważnych komplikacji neurologicznych. Zakażenia dróg moczowych są kolejnym powszechnym typem infekcji wywoływanych przez gronkowca, zwłaszcza u kobiet. Objawy tych stanów bywają dość subtelne, dlatego tak ważna jest wczesna diagnoza.
Gronkowiec może również prowadzić do bakteriemii, czyli obecności bakterii w krwi, co stanowi zagrożenie dla życia i może skutkować sepsą, wymagającą natychmiastowej interwencji medycznej. Dodatkowo, gronkowiec złocisty może być odpowiedzialny za rozwój ropni okołomigdałkowych, które często wymagają leczenia chirurgicznego.
Wiedza na temat typowych infekcji wywoływanych przez gronkowca jest kluczowa dla skutecznego zarządzania i leczenia takich przypadków. To zrozumienie może również pomóc zapobiegać poważnym powikłaniom, które mogą wystąpić w wyniku opóźnionej diagnozy czy niewłaściwej terapii. Z własnego doświadczenia mogę powiedzieć, że szybka reakcja na symptomy może znacząco wpłynąć na rokowanie pacjenta.
Jakie powikłania może powodować zakażenie gronkowcem?
Zakażenie gronkowcem może prowadzić do wielu poważnych komplikacji, które negatywnie wpływają na zdrowie pacjenta. Niewłaściwe leczenie zwiększa ryzyko:
- sepsy,
- zapalenia wsierdzia,
- zapalenia płuc.
Sepsa, jako reakcja organizmu na ciężką infekcję, może skutkować niewydolnością wielonarządową, co stanowi znaczące zagrożenie dla życia.
Przenoszenie gronkowca z miejsca infekcji do krwiobiegu to szczególnie niebezpieczny proces, który może prowadzić do bakteriemii – stanu, w którym bakterie są obecne we krwi. Takie okoliczności mogą skutkować dodatkowymi problemami zdrowotnymi, takimi jak:
- zapalenie otrzewnej,
- zapalenie opon mózgowo-rdzeniowych.
Warto również zaznaczyć, że zakażenia gronkowcem skórnym mogą wywołać zapalenie dróg moczowych, co wiąże się z kolejnymi komplikacjami.
Dlatego ważne jest, aby w przypadku podejrzenia zakażenia gronkowcem jak najszybciej zgłosić się do lekarza. Prawidłowa diagnoza i terapia mogą znacząco ograniczyć ryzyko dalszych powikłań zdrowotnych. Im szybciej zareagujemy na objawy zakażenia, tym mniejsze prawdopodobieństwo poważnych konsekwencji.
Jak diagnozuje się zakażenie gronkowcem?
Diagnoza zakażenia gronkowcem opiera się na wnikliwej analizie objawów klinicznych oraz wyników badań mikrobiologicznych. W przypadkach takich jak zatrucie pokarmowe, istotne jest przesłanie podejrzanych próbek żywności do laboratorium, co pozwala na identyfikację toksyn lub szczepów bakterii odpowiedzialnych za zatrucie.
Podstawowym narzędziem wykorzystywanym w diagnozowaniu jest posiew, który umożliwia izolację gronkowców z próbki pobranej od pacjenta—może to być krew, mocz, a czasem nawet tkanka z miejsca infekcji. Wiele zakażeń wymaga przeprowadzenia badań bakteriologicznych, które dostarczają istotnych informacji o rodzaju bakterii oraz ich wrażliwości na różne antybiotyki.
Co więcej, antybiogram odgrywa kluczową rolę w doborze odpowiedniej terapii. Dzięki niemu możemy określić, które antybiotyki będą skuteczne przeciwko danemu szczepowi gronkowca—co jest niezbędne dla zastosowania właściwego leczenia. Współpraca między lekarzami a laboratoriami mikrobiologicznymi ma fundamentalne znaczenie dla efektywnej diagnozy i terapii infekcji gronkowcowych.
Szybka reakcja na wyniki badań może znacząco zwiększyć efektywność leczenia.
Jakie metody leczenia gronkowca są stosowane?
Leczenie zakażeń gronkowcem zazwyczaj opiera się na stosowaniu antybiotyków, które powinny być dobrane zgodnie z wynikami badań bakteriologicznych oraz antybiogramu. Staranny wybór leku jest kluczowy, ponieważ różne szczepy gronkowca mogą wykazywać odmienną wrażliwość na dostępne środki.
Wśród najczęściej stosowanych antybiotyków w przypadku infekcji gronkowcowych znajdują się:
- klindamycyna,
- cefadroksyl,
- spiramycyna,
- mupirocyna,
- chloramfenikol.
Sposób ich zastosowania może się różnić, gdyż leki te mogą być podawane:
- miejscowo,
- doustnie,
- dożylnie.
Wszystko zależy od nasilenia zakażenia oraz oceny oporności bakterii na konkretne leki.
Przy zakażeniach związanych z implantami medycznymi czy protezami, często konieczne staje się ich usunięcie, ponieważ sama antybiotykoterapia może nie być wystarczająca. W wielu przypadkach, odpowiednio dobrana terapia prowadzi do całkowitego wyleczenia, dlatego tak istotne jest, aby lekarz skrupulatnie zbadał pacjenta i ustalił najbardziej efektywną metodę leczenia. Warto mieć na uwadze, że skuteczność terapii może zależeć od indywidualnych uwarunkowań pacjenta.
Jak działa antybiotykoterapia w leczeniu zakażeń gronkowcowych?
Antybiotykoterapia jest kluczowym elementem w walce z zakażeniami wywołanymi przez gronkowce. Gdy infekcja zostaje zidentyfikowana, istotne jest przeprowadzenie antybiogramu, który pozwala określić, które antybiotyki będą skuteczne przeciwko konkretnemu szczepowi bakterii. Selekcja odpowiedniego leku zależy nie tylko od intensywności infekcji, ale również od reakcji bakterii na zastosowane terapie.
Niestety, oporność na leki staje się coraz większym wyzwaniem w leczeniu zakażeń gronkowcowych, co czasami zmusza do poszukiwania alternatywnych rozwiązań. W niektórych przypadkach, obok farmakoterapii, konieczne mogą być zabiegi chirurgiczne, mające na celu:
- oczyszczenie ran,
- usunięcie zakażonej tkanki.
Na przykład, w sytuacjach związanych z infekcjami wokół protez, same antybiotyki mogą okazać się niewystarczające, co prowadzi do konieczności ich usunięcia.
Dodatkowo, stała kontrola i ocena skuteczności przeprowadzonej terapii są niezwykle ważne. Pozwalają one na szybką modyfikację leczenia, co z kolei zmniejsza ryzyko powikłań. Warto pamiętać, że szybsza reakcja na ewentualne niepowodzenia w terapii może znacząco poprawić rezultaty leczenia.
Jakie jest znaczenie oporności gronkowca na leki?
Oporność gronkowca na leki, zwłaszcza antybiotyki, odgrywa kluczową rolę w skuteczności terapii zakażeń. Rosnąca liczba szczepów odpornych na standardowe leczenie znacznie ogranicza jego efektywność, co zwiększa ryzyko powikłań. Przykładem tego wyzwania są szczepy takie jak Staphylococcus aureus oporny na metycylinę (MRSA), które są trudniejsze do zwalczenia. Walka z nimi może trwać dłużej, co prowadzi do dłuższych hospitalizacji i wyższych kosztów leczenia.
Niezwykle istotne jest śledzenie oporności gronkowca, co pozwala na dostosowanie terapii do aktualnych wyników badań. Dzięki temu lekarze mogą skuteczniej stawić czoła infekcjom. W praktyce klinicznej zmiany w schematach leczenia są często reakcją na wyniki obserwacji wzrastającej oporności na antybiotyki. Dla pacjentów z nawrotowymi zakażeniami, regularne badania mikrobiologiczne mogą znacznie przyspieszyć poprawę terapii.
Odpowiednie dostosowanie antybiotykoterapii jest niezbędne, by zredukować ryzyko nieskutecznych terapii i poprawić rezultaty leczenia. Zalecenia dotyczące terapii powinny opierać się na wynikach badań mikrobiologicznych, co z kolei umożliwia lekarzom efektywniejsze podejście do pacjentów z zakażeniami gronkowców. Co więcej, uwzględnienie lokalnych danych o oporności może znacząco wpłynąć na skuteczność podjętych działań terapeutycznych.
Jak zapobiegać zakażeniom gronkowcem?
Aby skutecznie chronić się przed zakażeniami gronkowcem, kluczowe jest przestrzeganie zasad higieny osobistej. Regularne mycie rąk wodą z mydłem po zetknięciu z zanieczyszczonymi powierzchniami oraz przed posiłkami znacznie obniża ryzyko infekcji. Dodatkowo, warto ograniczyć kontakt z osobami chorymi. W szpitalach szczególnie ważne jest stosowanie zasad izolacji kontaktowej.
Zdrowy styl życia ma ogromne znaczenie dla wzmocnienia odporności. Oto kluczowe elementy, które warto zrealizować:
- regularna aktywność fizyczna,
- zrównoważona dieta,
- odpowiednia ilość snu.
- unikać dzielenia się osobistymi przedmiotami,
- dbać o higienę osobistą.
Według mojego doświadczenia, nawet drobne zmiany w codziennym życiu mogą przynieść zauważalne korzyści dla zdrowia.
W szpitalnych warunkach, gdzie ryzyko zakażeń gronkowcowych jest wyższe, wdrażane są różne środki prewencyjne. Personel medyczny powinien ściśle przestrzegać zasad higieny rąk, a regularna dezynfekcja powierzchni kontaktowych jest podstawowym zadaniem ochronnym.
Konsekwentne stosowanie zasad higieny oraz dbałość o zdrowy styl życia to kluczowe elementy w zapobieganiu zakażeniom gronkowcem.
Jak wpływa higiena na zapobieganie i kontrolę zakażeń?
Higiena odgrywa kluczową rolę w zapobieganiu zakażeniom gronkowcem. Proste zasady, takie jak:
- regularne mycie rąk,
- dezynfekcja powierzchni,
- unikanie bliskiego kontaktu z osobami zakażonymi.
mogą znacząco obniżyć ryzyko infekcji. W miejscach szczególnie narażonych, jak placówki medyczne, personel powinien szczególnie troszczyć się o czystość rąk. Dezynfekcja dłoni przed i po każdym kontakcie z pacjentem oraz systematyczne czyszczenie narzędzi i powierzchni mają ogromne znaczenie w redukcji wskaźników zakażeń.
Edukcja dotycząca higieny w społeczeństwie oraz środowisku medycznym jest niezwykle istotna w walce z rozprzestrzenianiem się gronkowca. Regularne kampanie informacyjne i szkolenia, które podkreślają znaczenie:
- mycia rąk,
- dezynfekcji,
- zwiększania świadomości społecznej.
mogą znacznie zwiększyć skuteczność działań zapobiegawczych. Działania te w prosty sposób wpływają na poprawę bezpieczeństwa zarówno pacjentów, jak i personelu, co w rezultacie przyczynia się do lepszej kontroli zakażeń.













Najnowsze komentarze